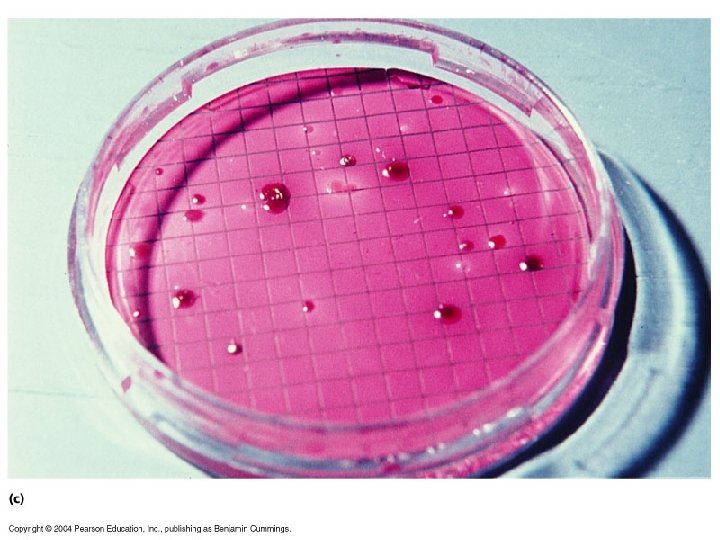

Nutricin Condiciones de Cultivo y Fases de Crecimiento

- Slides: 52
Nutrición, Condiciones de Cultivo y Fases de Crecimiento Temperatura: Psicrófilas: crecen óptimamente en temperaturas bajas < 20 grados C. Mesófilas: crecen óptimamente a temperatura ambiente > 20 - 40 grados C Flora normal del cuerpo= comensales Termófilas: Crecen a temperaturas altas
p. H Mayoría Bacterias patógenas: crecen en ambientes de Ph 6. 5 - 7. 5. Algunas toleran ambientes ácidos: flora gastrointestinal Otras como Vibrio cholerae crece en p. H alcalinos.
Requisitos de oxígeno Aeróbicos Anaeróbicos facultativos Microaerofílicos capneicos requieren más CO 2 que O 2 Anaeróbicos estrictos: oxígeno es letal
Gas Pak System Gas. Pak Plus® Hydrogen + CO 2 with Safety. Shielded Integral Palladium Catalyst Strip For CO 2 -enriched anaerobic environment.
Enlace http: //www. microbiologytext. com/index. php ? module=Book&func=displayarticle&art_id=7 5
http: //www. monografias. com/trabajos 27/cr ecimiento-bacteriano/crecimientobacteriano. shtml#ciclo
http: //www. javierhuertas. co m/PTMA-04 -05. html
Phases of Growth 4 Phases 1. Lag Phase 2. Log Phase 3. Stationary Phase 4. Death Phase
1. Lag Phase Bacteria are first introduced into an environment or media Bacteria are “checking out” their surroundings cells are very active metabolically # of cells changes very little 1 hour to several days
2. Log Phase Rapid cell growth (exponential growth) population doubles every generation microbes are sensitive to adverse conditions antibiotics anti-microbial agents
3. Stationary Phase Death rate = rate of reproduction cells begin to encounter environmental stress lack of nutrients lack of water not enough space metabolic wastes oxygen p. H Endospores would form now
3. Stationary Phase Death rate = rate of reproduction cells begin to encounter environmental stress lack of nutrients lack of water not enough space metabolic wastes oxygen p. H Endospores would form now
4. Death Phase Death rate > rate of reproduction Due to limiting factors in the environment
Curva de Crecimiento
Tiempo de Generación G= (t min) (log 2)/ log Bt – log B 0 Ejemplo: t= 135 min Log 2= Bt= 4. 5 X 10 8 B 0= 2. 83 X 10 7 G= 135 min X o. 301/ 8. 65 - 7. 45 G= 33. 8 min
Calcular factor de dilución Factor de dilución= ct + cb/ ct X cs Ejemplo: Si transfieres o. 1 ml en 99. 9 ml de agua y siembras 0. 1 ml, el factor de dilución es: 0. 1 ml + 99. 9 ml/ 0. 1 ml X 0. 1 ml 100/. 01 = FD= 10, 000
Metabolismo Autótrofos: producen su propio alimento Fotosintéticos CO 2+ 2 H 2 A CH 2 O + 2 A Ejs: CO 2 + 2 H 2 S CH 2 O + 2 S CO 2 + 2 S + 5 H 2 O 3 CH 2 O + 2 H 2 SO 4 CO 2 + 2 H 2 CH 2 O + H 2 O
Autótrofos NO fotosintéticos Thiobacillus: ( Oxida azufre) 2 S + 3 O 2 + 2 H 2 O 2 H 2 SO 4 Nitrosomonas: ( Oxida amonio) 2 NH 4 Cl + 3 O 2 2 HNO 2 + 2 HCl + 2 H 2 O Nitrobacter ( oxida nitritos) 2 Na. NO 2 + O 2 2 Na. NO 3
Metabolismo Heterótrofo Atacan materia preformada. Catabolizan moléculas Veamos el metabolismo de glucosa GLUCOLISIS= EMBDEN MEYERHOFF PATHWAY
Figure 9. 9 A closer look at glycolysis: energy investment phase (Layer 2)
Figure 9. 9 A closer look at glycolysis: energy payoff phase (Layer 3)
Figure 9. 9 A closer look at glycolysis: energy payoff phase (Layer 4)
Figure 9. 8 The energy input and output of glycolysis